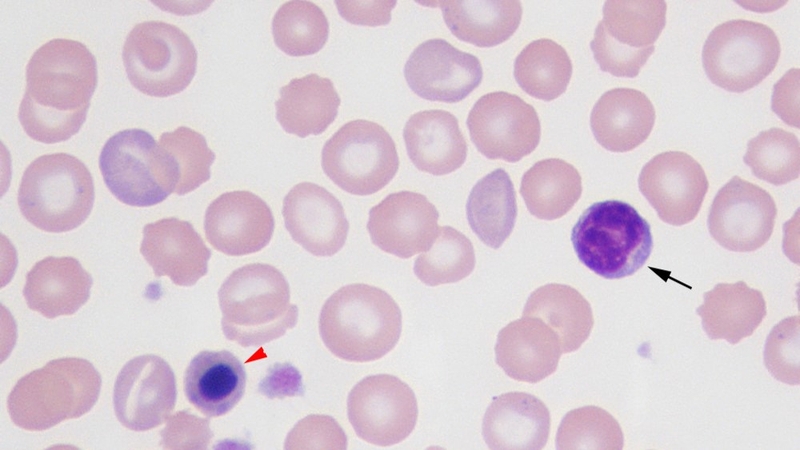
Nrbc là gì 1

Dược sĩ chuyên khoa Dược lý - Dược lâm sàng. Tốt nghiệp 2 trường đại học Mở và Y Dược TP. Hồ Chí Minh. Có kinh nghiệm nghiên cứu về lĩnh vực sức khỏe, đạt được nhiều giải thưởng khoa học. Hiện là Dược sĩ chuyên môn phụ trách xây dựng nội dung và triển khai dự án đào tạo - Hội đồng chuyên môn tại Nhà thuốc Long Châu.
NRBC là gì? Cách đọc kết quả xét nghiệm máu NRBC
Lan Anh
04/07/2024
Mặc định
Lớn hơn
NRBC là chỉ số trong xét nghiệm máu giúp đo lường số lượng và tỷ lệ hồng cầu lưới. Từ đó đánh giá về khả năng tái tạo hồng cầu từ tủy xương hoặc phát hiện một số vấn đề sức khỏe khác. Bài viết dưới đây sẽ giúp bạn hiểu rõ về NRBC là gì trong xét nghiệm máu.
Xét nghiệm NRBC là một phương pháp đơn giản nhưng có ý nghĩa lớn trong việc đánh giá tình trạng sức khỏe. Nó cung cấp nhiều thông tin quan trọng và là một công cụ đắc lực trong việc phát hiện các vấn đề sức khỏe từ sớm. Vậy NRBC là gì?
NRBC là gì?
Nhiều người thắc mắc “NRBC là gì?” khi xem kết quả xét nghiệm máu. Ký hiệu NRBC trong xét nghiệm máu là viết tắt của Nucleated Red Blood Cell hay còn gọi là hồng cầu còn nhân, hồng cầu non. Các tế bào máu này chưa trưởng thành và chưa hoàn thiện quá trình phát triển. Do đó chưa xuất hiện trong hệ thống tuần hoàn của cơ thể mà chỉ xuất hiện ở trẻ sơ sinh và sau đó biến mất trong vài tuần đầu sau khi sinh.
Ý nghĩa của chỉ số NRBC trong xét nghiệm máu
Sau khi biết về NRBC là gì, chúng ta tiếp tục tìm hiểu về ý nghĩa của chỉ số NRBC trong xét nghiệm máu. Máu là một trong những thành phần quan trọng nhất của cơ thể con người, chịu trách nhiệm vận chuyển khí oxy và các chất dinh dưỡng đến các mô và tế bào khác trong cơ thể. Mỗi lần chúng ta thực hiện xét nghiệm kiểm tra máu, nó không chỉ đo lường số lượng các thành phần máu chính như hồng cầu, bạch cầu và tiểu cầu mà còn theo dõi các chỉ số phụ như tế bào hồng cầu còn nhân (NRBC).
Trong quá trình tế bào máu được sản xuất, tế bào hồng cầu có nhân NRBC tồn tại trong thời gian rất ngắn trước khi bị loại bỏ nhân. Điều này thường xảy ra trong tuỷ xương trước khi tế bào hồng cầu trưởng thành lưu thông trong máu. Chỉ số NRBC không phổ biến trong xét nghiệm máu do trong điều kiện bình thường, tế bào hồng cầu không có nhân. Khi NRBC xuất hiện trong máu, đây có thể là dấu hiệu của bệnh:
- Rối loạn máu, bệnh bạch cầu hoặc tình trạng thiếu oxy nghiêm trọng (hypoxia - không đủ oxy trong các mô);
- Mất máu nhanh hoặc tế bào hồng cầu bị phá hủy nhiều trong thời gian ngắn dẫn đến việc gia tăng sản xuất hồng cầu nhanh chóng gây giải phóng NRBC vào máu;
- Hội chứng thalassemia hoặc di căn tủy xương từ khối u khác;
- Bệnh ung thư;
- Suy tim sung huyết.

Cách đọc kết quả xét nghiệm máu NRBC
Bên cạnh việc băn khoăn “NRBC là gì?”, nhiều người còn thắc mắc về cách đọc kết quả xét nghiệm máu chứa thành phần này. Tế bào hồng cầu có nhân (NRBC) thường không xuất hiện trong máu của người trưởng thành. Do đó, bất kỳ kết quả dương tính nào từ xét nghiệm NRBC đều cho thấy sự bất thường trong hệ thống máu của cơ thể và bác sĩ cần phải tìm ra nguyên nhân xuất hiện của NRBC. Thông thường, bác sĩ sẽ dựa vào ngưỡng từ 0,003 đến 0,01 x 10^9/L để đánh giá sự tăng cao của NRBC. Tuy nhiên, các nghiên cứu mới đây đã chỉ ra rằng, sự hiện diện của bất kỳ số lượng NRBC nào trong máu cũng có thể tăng nguy cơ tử vong đối với bệnh nhân.
Khi kết quả NRBC là dương tính, bác sĩ sẽ yêu cầu thực hiện thêm các xét nghiệm bổ sung bên cạnh việc thực hiện xét nghiệm tổng quan về thành phần máu ngoại vi như:
- Chụp MRI;
- Máy quét CT;
- PET scan để xác định có yếu tố di căn của ung thư hay không.
Tóm lại, chỉ số NRBC là một phần quan trọng của xét nghiệm huyết học toàn phần và thường là âm tính. Bất kỳ sự hiện diện nào của NRBC trong máu, dù là rất ít cũng đều gây ra lo lắng về tình trạng sức khỏe của bệnh nhân, bao gồm cả các vấn đề như rối loạn huyết học hoặc thiếu hụt oxy và đòi hỏi sự can thiệp của các chuyên gia y tế để tìm ra và điều trị, giảm thiểu nguy cơ tử vong cho bệnh nhân.
Cần làm gì để giảm chỉ số NRBC?
Để giảm chỉ số NRBC trong xét nghiệm máu, bạn cần tìm hiểu và điều trị nguyên nhân cụ thể dẫn đến sự tăng sản xuất chỉ số này. Dưới đây là các biện pháp có thể được cân nhắc thực hiện:
- Điều trị bệnh tận gốc: Nếu sự tăng sản xuất NRBC liên quan đến một tình trạng bệnh lý cụ thể, như thiếu máu, bệnh thalassemia hay bất kỳ bệnh lý nào khác, việc điều trị bệnh tận gốc sẽ là bước quan trọng nhất. Điều này bao gồm việc sử dụng thuốc, điều chỉnh chế độ ăn uống hoặc là điều trị bằng phẫu thuật, tùy thuộc vào tình trạng sức khỏe của bệnh nhân.
- Chăm sóc sức khỏe: Cải thiện chế độ ăn uống và tăng cường hoạt động thể chất có thể giúp cải thiện sức khỏe tổng thể và hỗ trợ quá trình sản xuất máu. Đảm bảo bạn đang tiêu thụ đủ lượng chất dinh dưỡng cần thiết, bao gồm sắt, axit folic và vitamin B12.
- Theo dõi định kỳ: Thực hiện các xét nghiệm máu định kỳ để theo dõi sự biến đổi của chỉ số NRBC và đánh giá hiệu quả của phương pháp điều trị.

Bài viết trên đây đã giúp bạn tìm hiểu về chỉ số NRBC là gì. Hiện nay, xét nghiệm máu tổng quát là một trong những phương pháp chẩn đoán phổ biến, giúp theo dõi và phát hiện nhiều bệnh lý khác nhau. Nếu bạn có bất kỳ dấu hiệu hoặc nghi ngờ nào về tình trạng sức khỏe của mình, hãy đến ngay các cơ sở khám chữa bệnh để được tư vấn và điều trị chính xác nhất.
Có thể bạn quan tâm
Các bài viết liên quan
Khám lâm sàng và cận lâm sàng khác nhau như thế nào?
Giá trị của các khoảng tham chiếu trong xét nghiệm máu
Xét nghiệm sán lá gan nhỏ: Phương pháp chẩn đoán và cách phòng ngừa
Xét nghiệm giun đũa: Khi nào cần thực hiện, các phương pháp xét nghiệm?
Xét nghiệm sán lá gan lớn: Chẩn đoán và quy trình xét nghiệm
Tăng chuyển hóa FDG là gì? Nguyên nhân gây tăng chuyển hóa FDG
Định lượng PSA toàn phần là gì? Ý nghĩa và khi nào cần xét nghiệm
Xét nghiệm ký sinh trùng bao nhiêu tiền? Những điều cần biết
Chỉ số máu CA 125 cao uống gì thì giảm?
Xét nghiệm trisure 9.5 giá bao nhiêu và có chính xác không?
:format(webp)/Option_1_2_2d9677e5fd.png)
:format(webp)/Option_1_1_2a84e0cd00.png)
:format(webp)/tran_huynh_minh_nhat_905ca436dd.png)